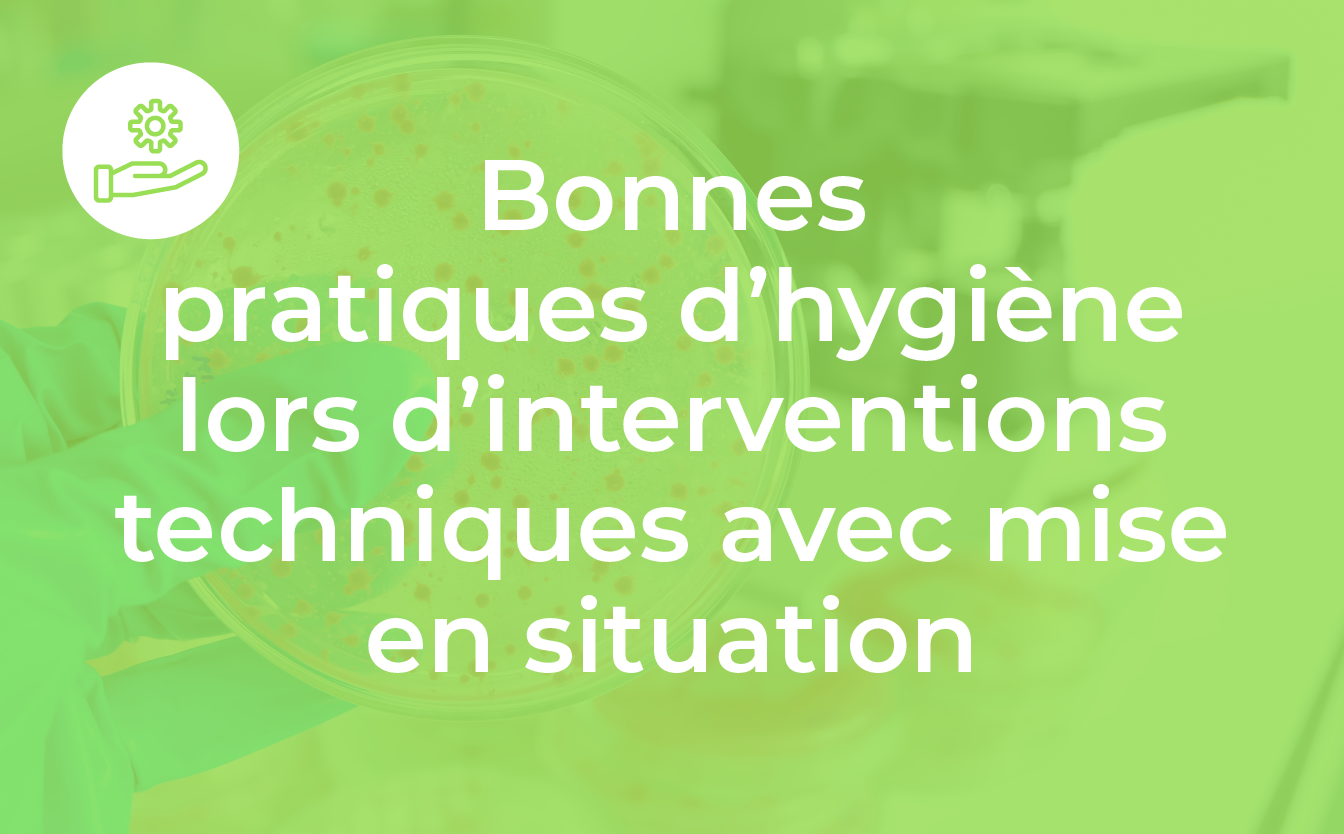
En savoir plus

Maitrise du risque infectieux lié à l'environnement
Recherche >>
Vous pouvez retrouver ci-dessous l'ensemble de nos prestations dispensées sur la maîtrise du risque infectieux lié à l'environnement. Certaines de nos prestations sont réalisables dans le cadre du DPC (Développement Personnel Continu). Nous vous invitons à cliquer sur le titre d'une prestation pour découvrir le programme.
L'icone  indique que la prestation contient une partie de pratique en laboratoire.
indique que la prestation contient une partie de pratique en laboratoire.
Nos formations
Nos audits
Nous contacter
Eurofins Environnement Formation et Conseil SAS
✉ formation-germande@etfr.eurofins.com
☎ 07 87 38 75 87
505, rue Louis Berton, Bât. 2, 13590 Aix-en-Provence
Contactez-nous
Conditions Générales de Ventes






La certification qualité a été délivrée au titre de la catégorie d'actions suivantes : action de formations